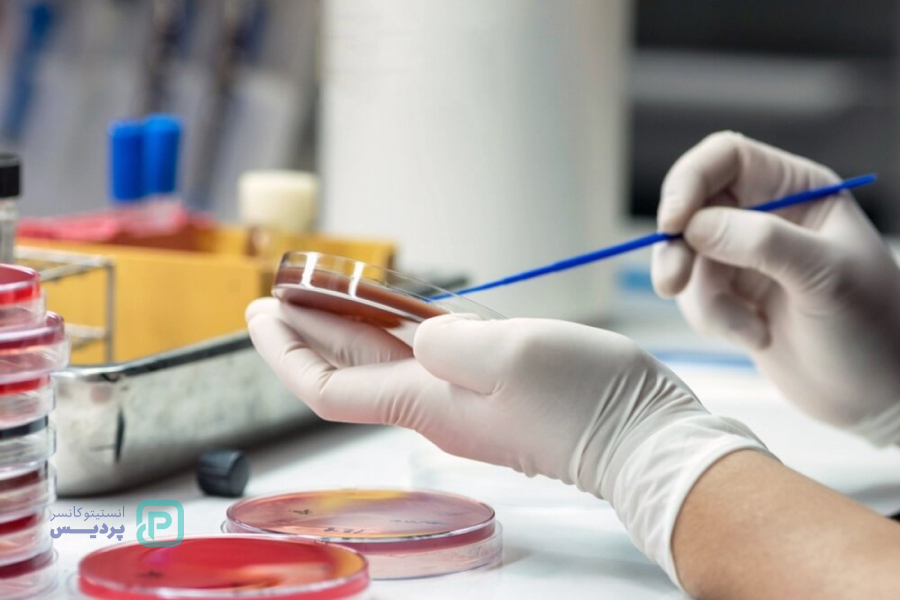
طول عمر بیماران سرطان خون

سرطان خون، که به عنوان لوسمی نیز شناخته میشود، نوعی سرطان است که سلولهای خونی و مغز استخوان را تحت تأثیر قرار میدهد. این سلولها نقش حیاتی در سیستم ایمنی بدن و تولید گلبولهای قرمز و پلاکت دارند. در سرطان خون، سلولهای غیرطبیعی به طور غیرقابل کنترلی تکثیر میشوند و عملکرد سلولهای سالم را مختل میکنند. برخلاف تصورات رایج، امید به زندگی در مبتلایان به سرطان خون در عصر حاضر به طور قابل توجهی افزایش یافته است. به طوری که میانگین طول عمر آنها بیش از 5 سال است. این آمار نشاندهنده پیشرفتهای چشمگیر در روشهای درمانی و افزایش شانس بقا در این بیماری است.
آنچه در ادامه خواهید خواند:
طول عمر بیماران سرطان خون:
به طور کلی، نرخ بقای پنج ساله برای همه انواع لوسمی 61.4 درصد است. این بدان معناست که از هر 100 نفر مبتلا به سرطان خون، 61 نفر بعد از 5 سال همچنان زنده هستند. با این حال، این فقط یک میانگین است و به هیچ وجه پیشبینی دقیقی از آنچه برای هر فرد اتفاق میافتد، نیست. پیشرفتهای اخیر در درمان سرطان خون، امید به زندگی بیماران را به طور قابلتوجهی افزایش داده است. تحقیقات و مطالعات جدید همچنان در حال انجام است تا روشهای درمانی جدید و موثرتری برای این بیماری کشف شود.
کلینیک پردیس شیراز (انستیتو کانسر پردیس) بزرگترین مرکز پزشکی تشخیص و درمان سرطان در جنوب کشور است که در زمینه های مختلف پیشگیری و درمان سرطان، دیابت، بیماری های قلبی و عروقی و … خدمت رسانی می کند. همچنین این مرکز به عنوان یکی از بهترین مراکز تصویر برداری شیراز، خدمات متنوعی از جمله سی تی اسکن کنسر، سونوگرافی، رادیولوژی، ماموگرافی و سنجش تراکم استخوان را ارائه میدهد. جهت مشاوره رایگان و کسب اطلاعات بیشتر می توانید از طریق شماره 07191003888 و یا صفحه تماس با ما، با مجموعه درمانی پردیس در ارتباط باشید.
طول عمر بیماران سرطان خون
سرطان خون، بیماری پیچیدهای است که با تکثیر غیرطبیعی سلولهای خونی مشخص میشود. انواع سرطان خون وجود دارد که هر کدام ویژگیهای خاص خود را دارند. پیشبینی طول عمر در بیماران مبتلا به سرطان خون به عوامل مختلفی از جمله نوع سرطان خون، سن بیمار، وضعیت سلامتی کلی، مرحله بیماری و پاسخ به درمان بستگی دارد.

مطالعات گذشته نشان داده که:
- عود زودهنگام: در صورتی که بیماری پس از درمان اولیه عود کند، شانس زنده ماندن بیمار در 5 سال بعد از عود 21% خواهد بود.
- عود جدا شده مغز استخوان: در این نوع عود، بیماری فقط در مغز استخوان دوباره ظاهر میشود. شانس زنده ماندن در 5 سال بعد از این نوع عود بین 11.5 تا 43.5 درصد متغیر است و به زمان عود بستگی دارد.
- عود جدا شده سیستم عصبی مرکزی: در این نوع عود، بیماری فقط در سیستم عصبی مرکزی (CNS) دوباره ظاهر میشود. شانس زنده ماندن در 5 سال بعد از این نوع عود بین 43.5 تا 78 درصد متغیر است و همچنان به زمان عود بستگی دارد.
*نکته:
- این آمار و ارقام فقط بر اساس مطالعات گذشته هستند و ممکن است در مورد هر بیمار متفاوت باشد.
- هر کودک منحصر به فرد است و روند درمان و پیش آگهی او نیز میتواند متفاوت باشد.
عوامل مؤثر بر پیشآگهی و بقا در سرطان خون کودکان
با پیشرفتهای روزافزون در تشخیص علائم سرطان خون در کودکان و درمان، شانس زنده ماندن کودکان مبتلا به این بیماری به طور قابل توجهی افزایش یافته است. تحقیقات و مطالعات جدید همچنان در حال انجام است تا روشهای درمانی جدید و موثرتری برای این بیماری کشف شود.

عوامل تاثیرگذار بر طول عمر فرد مبتلا به سرطان خون
عوامل فردی بسیاری نیز وجود دارد که بر پیش آگهی و بقای افراد مبتلا به انواع لوسمی تأثیر میگذارند، از جمله این عوامل میتوان به موارد زیر اشاره کرد:
- سن در هنگام تشخیص سرطان خون: کودکان به طور کلی پیشآگهی بهتری نسبت به بزرگسالان دارند.
- تعداد گلبولهای سفید خون (WBC): سطوح بالای WBC در هنگام تشخیص با پیشآگهی ضعیفتر مرتبط است.
- وجود ناهنجاریهای ژنتیکی: برخی از جهشهای ژنتیکی خاص در سلولهای سرطانی میتوانند بر اثربخشی درمان و بقاء بیمار تأثیر منفی بگذارند.
- بیماری سیستم عصبی مرکزی (CNS): درگیری CNS با سلولهای سرطانی، پیشآگهی را بدتر میکند.
- پاسخ به درمان: بیمارانی که به درمان سرطان خون به خوبی پاسخ میدهند، شانس بیشتری برای زنده ماندن در بلندمدت دارند.
پیشرفتهای نوین در تشخیص و درمان لوسمی
- درک عمیقتر از ژنتیک مولکولی و پاتوفیزیولوژی بیماری: شناخت دقیقتر مکانیسمهای مولکولی به طراحی درمانهای هدفمند و مؤثرتر کمک کرده است.
- اندازهگیری بیماری باقیمانده (MRD): با استفاده از روشهای حساس مانند ایمونوفنوتیپینگ جریان و PCR مولکولی، میتوان میزان سلولهای سرطانی باقیمانده در بدن را پس از درمان اندازهگیری کرد. این امر به پزشکان کمک میکند تا به طور دقیقتر به اثربخشی درمان پی ببرند و در صورت نیاز، استراتژی درمانی را تنظیم کنند.
- بهبود الگوریتمهای درمانی مبتنی بر ریسک: با توجه به ویژگیهای فردی بیمار، مانند سن، وضعیت ژنتیکی و پاسخ به درمان، میتوان برنامههای درمانی متناسب با هر فرد را طراحی کرد. این امر به افزایش شانس موفقیت درمان و کاهش عوارض جانبی کمک میکند.
- پیشرفت در توسعه عوامل درمانی: نوآوری در زمینه داروهای ضدسرطان، مانند ایمونوتراپی و درمانهای هدفمند، امید جدیدی را برای بیماران مبتلا به لوسمی به ارمغان آورده است.
- استفاده از پیوند سلولهای بنیادی هماتوپوئیتیک آلوژنیک: در برخی موارد، پیوند سلولهای بنیادی از یک فرد سالم به بیمار میتواند به عنوان راه حلی نجاتبخش عمل کند.

در سایت medicalnewstoday درباره طول عمر بیماران سرطان خون به شرح زیر آمده است:
The latest figures show that the 5-year survival rate for all subtypes of leukemia is 65.7%Trusted Source. A 5-year survival rate looks at how many people are still alive 5 years after their diagnosis.
Leukemia is most common in older adults, with incidence rates rising sharply from around 55 years. In the United Kingdom, between 2016–2018, roughly 4 in 10 new cases were in individuals aged 75 and over. The highest rates occur in people in the 85–89 age group.

کلینیک کانسر پردیس، همراه شما در مسیر مبارزه با سرطان خون
سرطان خون، بیماری پیچیدهای است که با وجود پیشرفتهای چشمگیر در علم پزشکی، همچنان چالشهای زیادی را برای بیماران به همراه دارد. انتخاب مرکز درمانی مناسب و مجرب، نقش مهمی در افزایش شانس موفقیت درمان و ارتقای کیفیت زندگی بیماران مبتلا به این بیماری ایفا میکند. کلینیک کانسر پردیس با بهرهمندی از کادر مجرب و متخصص، تجهیزات پیشرفته و روشهای درمانی نوین در صدر جدول مبارزه با سرطان خون قرار دارد.
خدمات کلینیک کانسر پردیس در زمینه تشخیص و درمان سرطان خون:
- تشخیص دقیق: با استفاده از جدیدترین تستهای آزمایشگاهی و تصویربرداری، به طور دقیق نوع و مرحله سرطان خون را در شما تشخیص میدهیم.
- درمانهای هدفمند: با توجه به ویژگیهای فردی شما، بهترین و موثرترین روشهای درمانی را برای شما تجویز میکنیم.
- پایش مستمر: در طول دوره درمان، به طور مرتب وضعیت شما را پایش میکنیم و در صورت نیاز، برنامه درمانی را تنظیم میکنیم.
با انتخاب کلینیک کانسر پردیس، به امید و زندگی دوباره در مسیر مبارزه با سرطان خون سلام کنید.
برای کسب اطلاعات بیشتر و رزرو وقت مشاوره، با ما تماس بگیرید.
- شماره تماس: 07191003888
- آدرس: فارس، شیراز، تقاطع باهنر جنوبی انستیتو کانسر پردیس
- وب سایت: pardiscancer.com


بدون دیدگاه